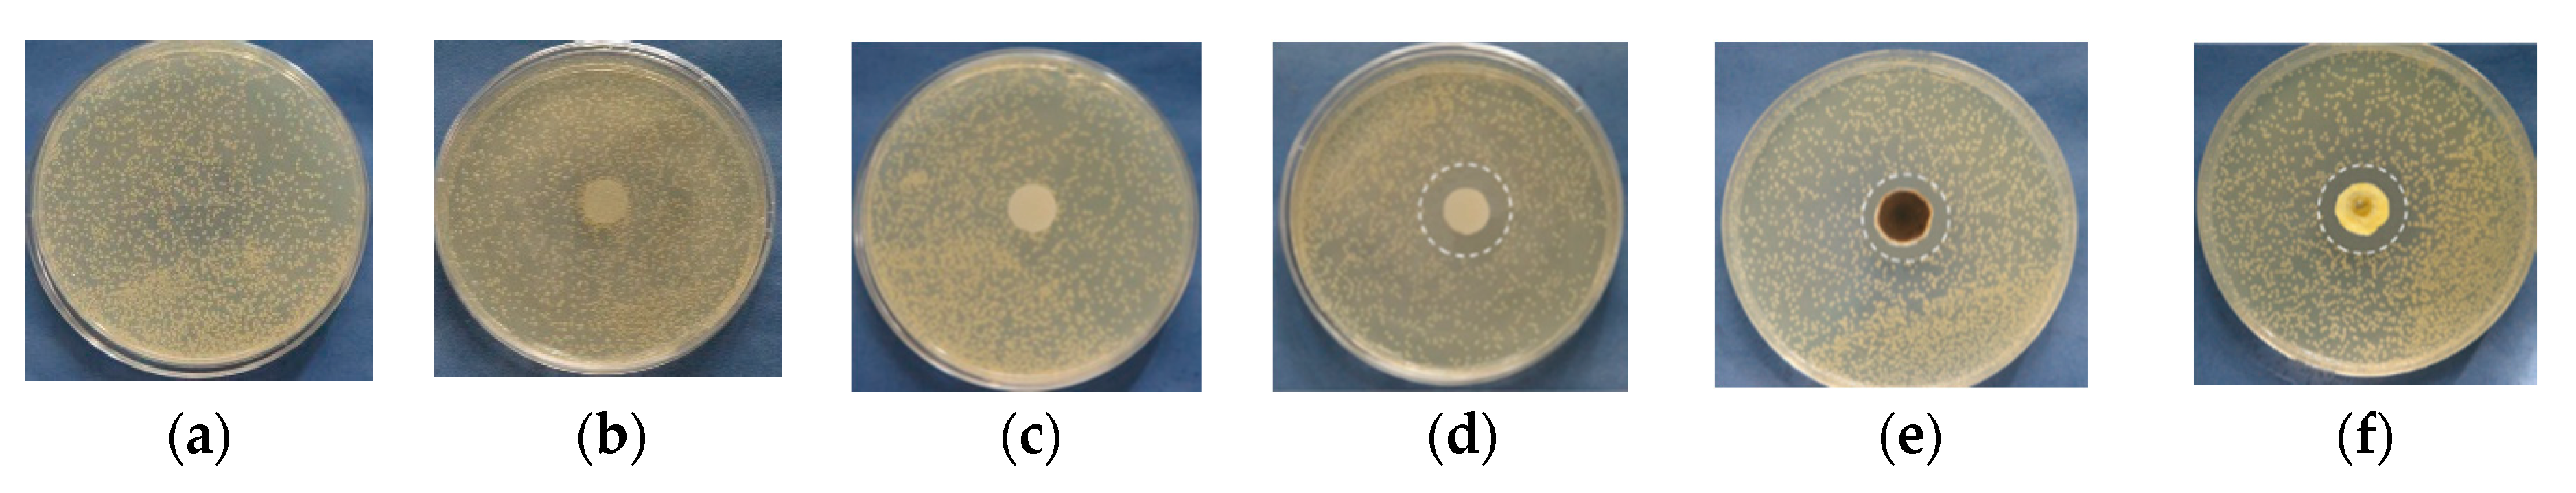
Polymers 13 02690 g008a

8-Hydroxyquinoline-5-Sulfonic Acid-Containing Poly(Vinyl Alcohol)/Chitosan Electrospun Materials and Their Cu2+ and Fe3+ Complexes: Preparation, Antibacterial, Antifungal and Antitumor Activities
Abstract
1. Introduction
2. Materials and Methods
2.1. Materials
2.2. Preparation of the Fibrous Materials
2.2.1. Preparation of PVA/Ch Mats
2.2.2. Preparation of PVA/Ch/SQ Mats
2.3. Crosslinking of the PVA/Ch and PVA/Ch/SQ Mats
2.4. Preparation of Cu2+(Fe3+) Complexes of cr(PVA/Ch)/SQ Mats and of SQ
2.5. Characterization
2.6. In Vitro SQ, SQ.Cu2+ and SQ.Fe3+ Release
2.7. Microbiological Tests
2.8. MTT Cytotoxicity Assay
2.9. Studying Apoptosis by Fluorescent Staining Methods
2.9.1. Double Staining Assay with AO and EtBr
2.9.2. DAPI Staining
2.10. Statistical Analysis
3. Results and Discussion
3.1. Morphology of the Fibrous Materials
3.2. ATR-FTIR Analysis of the Fibrous Materials
3.3. Thermal Characteristics of the Fibrous Materials
3.4. Water Contact Angle of the Fibrous Materials
3.5. XPS Analysis of the Fibrous Materials
3.6. EPR Analysis of Cu2+ and Fe3+ Complexes of the Fibrous Materials
3.7. In Vitro SQ, SQ.Cu2+ and SQ.Fe3+ Release Studies
3.8. Evaluation of the Antibacterial and Antifungal Activity of the Fibrous Materials
3.9. Study of the Adhesion of S. aureus Cells to the Surface of the Fibrous Materials
3.10. Cytotoxicity of the Fibrous Mats against Human HeLa Tumor Cells
4. Conclusions
Supplementary Materials
Author Contributions
Funding
Institutional Review Board Statement
Informed Consent Statement
Data Availability Statement
Acknowledgments
Conflicts of Interest
References
- Greiner, A.; Wendorff, J.H. Electrospinning: A Fascinating Method for the Preparation of Ultrathin Fibers. Angew. Chem. Int. Ed. 2007, 46, 5670–5703. [Google Scholar] [CrossRef] [PubMed]
- Kriegel, C.; Arrechi, A.; Kit, K.; McClements, D.; Weiss, J. Fabrication, Functionalization, and Application of Electrospun Biopolymer Nanofibers. Crit. Rev. Food Sci. Nutr. 2008, 48, 775–797. [Google Scholar] [CrossRef]
- Calamak, S.; Shahbazi, R.; Eroğlu, I.; Gultekinoglu, M.; Ulubayram, K. An overview of nanofiber-based antibacterial drug design. Expert Opin. Drug Discov. 2017, 12, 391–406. [Google Scholar] [CrossRef] [PubMed]
- Luraghi, A.; Peri, F.; Moroni, L. Electrospinning for drug delivery applications: A review. J. Control. Release 2021, 334, 463–484. [Google Scholar] [CrossRef] [PubMed]
- Wang, C.; Wang, J.; Zeng, L.; Qiao, Z.; Liu, X.; Liu, H.; Zhang, J.; Ding, J. Fabrication of Electrospun Polymer Nanofibers with Diverse Morphologies. Molecules 2019, 24, 834. [Google Scholar] [CrossRef]
- Balaji, A.; Vellayappan, M.V.; John, A.A.; Subramanian, A.P.; Jaganathan, S.K.; Supriyanto, E.; Razak, S.I.A. An insight on electrospun-nanofibers-inspired modern drug delivery system in the treatment of deadly cancers. RSC Adv. 2015, 5, 57984–58004. [Google Scholar] [CrossRef]
- Ulubayram, K.; Calamak, S.; Shahbazi, R.; Eroğlu, I. Nanofibers Based Antibacterial Drug Design, Delivery and Applications. Curr. Pharm. Des. 2015, 21, 1930–1943. [Google Scholar] [CrossRef]
- Chou, S.-F.; Carson, D.; Woodrow, K.A. Current strategies for sustaining drug release from electrospun nanofibers. J. Control. Release 2015, 220, 584–591. [Google Scholar] [CrossRef]
- Dizaj, S.M.; Sharifi, S.; Jahangiri, A. Electrospun nanofibers as versatile platform in antimicrobial delivery: Current state and perspectives. Pharm. Dev. Technol. 2019, 24, 1187–1199. [Google Scholar] [CrossRef]
- Poláková, L.; Širc, J.; Hobzová, R.; Cocârță, A.-I.; Heřmánková, E. Electrospun nanofibers for local anticancer therapy: Review of in vivo activity. Int. J. Pharm. 2019, 558, 268–283. [Google Scholar] [CrossRef]
- Hu, X.; Liu, S.; Zhou, G.; Huang, Y.; Xie, Z.; Jing, X. Electrospinning of polymeric nanofibers for drug delivery applications. J. Control. Release 2014, 185, 12–21. [Google Scholar] [CrossRef]
- Ignatova, M.; Rashkov, I.; Manolova, N. Drug-loaded electrospun materials in wound-dressing applications and in local cancer treatment. Expert Opin. Drug Deliv. 2013, 10, 469–483. [Google Scholar] [CrossRef]
- Li, J.; Cai, C.; Li, J.; Li, J.; Li, J.; Sun, T.; Wang, L.; Wu, H.; Yu, G. Chitosan-based nanomaterials for drug delivery. Molecules 2018, 23, 2661. [Google Scholar] [CrossRef]
- Jayakumar, R.; Menon, D.; Manzoor, K.; Nair, S.; Tamura, H. Biomedical applications of chitin and chitosan based nanomaterials—A short review. Carbohydr. Polym. 2010, 82, 227–232. [Google Scholar] [CrossRef]
- Paneva, D.; Ignatova, M.; Manolova, N.; Rashkov, I. Novel chitosan–containing micro- and nanofibrous materials by electrospinning: Preparation and biomedical application. In Nanofibers: Fabrication, Performance, and Applications; Chang, W.N., Ed.; Nova Science Publishers: New York, NY, USA, 2009; pp. 73–151. [Google Scholar]
- Liu, X.F.; Guan, Y.L.; Yang, D.Z.; Li, Z.; De Yao, K. Antibacterial action of chitosan and carboxymethylated chitosan. J. Appl. Polym. Sci. 2000, 79, 1324–1335. [Google Scholar] [CrossRef]
- Qin, C.; Du, Y.; Xiao, L.; Li, Z.; Gao, X. Enzymic preparation of water-soluble chitosan and their antitumor activity. Int. J. Biol. Macromol. 2002, 31, 111–117. [Google Scholar] [CrossRef]
- Peña, A.; Sánchez, N.S.; Calahorra, M. Effects of Chitosan on Candida albicans: Conditions for Its Antifungal Activity. BioMed Res. Int. 2013, 2013, 1–15. [Google Scholar] [CrossRef]
- Spasova, M.; Manolova, N.; Paneva, D.; Rashkov, I. Preparation of chitosan-containing nanofibres by electrospinning of chitosan/poly(ethylene oxide) blend solutions. e-Polymers 2004, 4, 624–635. [Google Scholar] [CrossRef]
- Duan, B.; Dong, C.; Yuan, X.; Yao, K. Electrospinning of chitosan solutions in acetic acid with poly (ethylene oxide). J. Biomater. Sci. Polym. Ed. 2004, 15, 797–811. [Google Scholar] [CrossRef]
- Ohkawa, K.; Cha, D.; Kim, H.; Nishida, A.; Yamamoto, H. Electrospinning of Chitosan. Macromol. Rapid Commun. 2004, 25, 1600–1605. [Google Scholar] [CrossRef]
- Schiffman, J.; Schauer, C. Cross-Linking Chitosan Nanofibers. Biomacromolecules 2007, 8, 594–601. [Google Scholar] [CrossRef]
- Schiffman, J.D.; Schauer, C.L. One-step electrospinning of cross-linked chitosan fibers. Biomacromolecules 2007, 8, 2665–2667. [Google Scholar] [CrossRef]
- Fathollahipour, S.; Mehrizi, A.A.; Ghaee, A.; Koosha, M. Electrospinning of PVA/chitosan nanocomposite nanofibers containing gelatin nanoparticles as a dual drug delivery system. J. Biomed. Mater. Res. A 2015, 103, 3852–3862. [Google Scholar] [CrossRef]
- Abbaspour, M.; Makhmalzadeh, B.S.; Rezaee, B.; Shoja, S.; Ahangari, Z. Evaluation of the Antimicrobial Effect of Chitosan/Polyvinyl Alcohol Electrospun Nanofibers Containing Mafenide Acetate. Jundishapur J. Microbiol. 2015, 8, e24239. [Google Scholar] [CrossRef]
- Wang, M.; Roy, A.K.; Webster, T.J. Development of Chitosan/Poly (Vinyl Alcohol) Electrospun Nanofibers for Infection Related Wound Healing. Front. Physiol. 2017, 7, 683. [Google Scholar] [CrossRef]
- Cui, Z.; Zheng, Z.; Lin, L.; Si, J.; Wang, Q.; Peng, X.; Chen, W. Electrospinning and crosslinking of polyvinyl alcohol/chitosan composite nanofiber for transdermal drug delivery. Adv. Polym. Technol. 2017, 37, 1917–1928. [Google Scholar] [CrossRef]
- Patel, G.; Yadav, B.K.N. Formulation, Characterization and In Vitro Cytotoxicity of 5-Fluorouracil Loaded Polymeric Electrospun Nanofibers for the Treatment of Skin Cancer. Recent Patents Nanotechnol. 2019, 13, 114–128. [Google Scholar] [CrossRef]
- Liu, Q.; Ouyang, W.-C.; Zhou, X.-H.; Jin, T.; Wu, Z.-W. Antibacterial Activity and Drug Loading of Moxifloxacin-Loaded Poly (Vinyl Alcohol)/Chitosan Electrospun Nanofibers. Front. Mater. 2021, 8. [Google Scholar] [CrossRef]
- Thien, D.V.H.; Quyen, T.T.B.; Tri, N.M.; Thoa, T.T.K.; Tham, N.T.N. Electrospun chitosan/PVA nanofibers for drug delivery. J. Sci. Technol. 2016, 54, 185–192. [Google Scholar] [CrossRef]
- Song, Y.; Xu, H.; Chen, W.; Zhan, P.; Liu, X. 8-Hydroxyquinoline: A privileged structure with a broad-ranging pharmacological potential. MedChemComm 2014, 6, 61–74. [Google Scholar] [CrossRef]
- Prachayasittikul, V.; Prachayasittikul, V.; Prachayasittikul, S.; Ruchirawat, S. 8-Hydroxyquinolines: A review of their metal chelating properties and medicinal applications. Drug Des. Dev. Ther. 2013, 7, 1157–1178. [Google Scholar] [CrossRef] [PubMed]
- Al-Busafi, S.N.; Suliman, F.E.O.; Al-Alawi, Z.R. 8-Hydroxyquinoline and Its Derivatives: Synthesis and Applications. Res. Rev. J. Chem. 2014, 45. [Google Scholar] [CrossRef]
- Tanzer, J.M.; Slee, A.M.; Kamay, B.; Scheer, E. Activity of Three 8-Hydroxyquinoline Derivatives against In Vitro Dental Plaque. Antimicrob. Agents Chemother. 1978, 13, 1044–1045. [Google Scholar] [CrossRef] [PubMed]
- Spasova, M.; Manolova, N.; Markova, N.; Rashkov, I. Superhydrophobic PVDF and PVDF-HFP nanofibrous mats with antibacterial and anti-biofouling properties. Appl. Surf. Sci. 2016, 363, 363–371. [Google Scholar] [CrossRef]
- Toncheva, A.; Mincheva, R.; Kancheva, M.; Manolova, N.; Rashkov, I.; Dubois, P.; Markova, N. Antibacterial PLA/PEG electrospun fibers: Comparative study between grafting and blending PEG. Eur. Polym. J. 2016, 75, 223–233. [Google Scholar] [CrossRef]
- Stoyanova, N.; Paneva, D.; Mincheva, R.; Toncheva, A.; Manolova, N.; Dubois, P.; Rashkov, I. Poly (l-lactide) and poly (butylene succinate) immiscible blends: From electrospinning to biologically active materials. Mater. Sci. Eng. C 2014, 41, 119–126. [Google Scholar] [CrossRef]
- Mincheva, R.; Manolova, N.; Paneva, D.; Rashkov, I. Preparation of Polyelectrolyte-Containing Nanofibers by Electrospinning in the Presence of a Non-Ionogenic Water-Soluble Polymer. J. Bioact. Compat. Polym. 2005, 20, 419–435. [Google Scholar] [CrossRef]
- Spasova, M.; Manolova, N.; Rashkov, I.; Naydenov, M. Electrospun 5-chloro-8-hydroxyquinoline-Loaded Cellulose Acetate/Polyethylene Glycol Antifungal Membranes against Esca. Polymers 2019, 11, 1617. [Google Scholar] [CrossRef]
- Spasova, M.; Manolova, N.; Rashkov, I.; Tsekova, P.; Georgieva, A.; Toshkova, R.; Markova, N. Cellulose Acetate-Based Electrospun Materials with a Variety of Biological Potentials: Antibacterial, Antifungal and Anticancer. Polymers 2021, 13, 1631. [Google Scholar] [CrossRef]
- Ignatova, M.; Stoilova, O.; Manolova, N.; Markova, N.; Rashkov, I. Electrospun Mats from Styrene/Maleic Anhydride Copolymers: Modification with Amines and Assessment of Antimicrobial Activity. Macromol. Biosci. 2010, 10, 944–954. [Google Scholar] [CrossRef]
- Ignatova, M.; Stoyanova, N.; Manolova, N.; Rashkov, I.; Kukeva, R.; Stoyanova, R.; Toshkova, R.; Georgieva, A. Electrospun materials from polylactide and Schiff base derivative of Jeffamine ED® and 8-hydroxyquinoline-2-carboxaldehyde and its complex with Cu2+: Preparation, antioxidant and antitumor activities. Mat. Sci. Eng. C 2020, 116, 111185. [Google Scholar] [CrossRef]
- Pippi, B.; Reginatto, P.; Da Rosa Monte Machado, G.; Bergamo, V.Z.; Lana, D.F.D.; Teixeira, M.L.; Franco, L.L.; Alves, R.J.; Andrade, S.F.; Fuentefria, A.M. Evaluation of 8-Hydroxyquinoline Derivatives as Hits for Antifungal Drug Design. Med. Mycol. 2017, 55, 763–773. [Google Scholar] [CrossRef]
- Pippi, B.; Lopes, W.; Reginatto, P.; Silva, F.K.; Joaquim, A.R.; Alves, R.J.; Silveira, G.P.; Vainstein, M.H.; Andrade, S.F.; Fuentefria, A.M. New insights into the mechanism of antifungal action of 8-hydroxyquinolines. Saudi Pharm. J. 2018, 27, 41–48. [Google Scholar] [CrossRef] [PubMed]
- Kuchárová, V.; Kuchár, J.; Zaric, M.; Canovic, P.; Arsenijevic, N.; Volarevic, V.; Misirkic, M.; Trajkovic, V.; Radojević, I.D.; Čomić, L.R.; et al. Low-dimensional compounds containing bioactive ligands. Part XI: Synthesis, structures, spectra, in vitro anti-tumor and antimicrobial activities of 3d metal complexes with 8-hydroxyquinoline-5-sulfonic acid. Inorganica Chim. Acta 2019, 497. [Google Scholar] [CrossRef]
- Jiang, H.; Taggart, J.E.; Zhang, X.; Benbrook, D.M.; Lind, S.E.; Ding, W.-Q. Nitroxoline (8-hydroxy-5-nitroquinoline) is more a potent anti-cancer agent than clioquinol (5-chloro-7-iodo-8-quinoline). Cancer Lett. 2011, 312, 11–17. [Google Scholar] [CrossRef]
- Barilli, A.; Atzeri, C.; Bassanetti, I.; Ingoglia, F.; Dall’Asta, V.; Bussolati, O.; Maffini, M.; Mucchino, C.; Marchiò, L. Oxidative Stress Induced by Copper and Iron Complexes with 8-Hydroxyquinoline Derivatives Causes Paraptotic Death of HeLa Cancer Cells. Mol. Pharm. 2014, 11, 1151–1163. [Google Scholar] [CrossRef]
- Ignatova, M.; Starbova, K.; Markova, N.; Manolova, N.; Rashkov, I. Electrospun nano-fibre mats with antibacterial properties from quaternised chitosan and poly (vinyl alcohol). Carbohydr. Res. 2006, 341, 2098–2107. [Google Scholar] [CrossRef] [PubMed]
- Gubendran, A.; Kesavan, M.P.; Ayyanaar, S.; Raja, J.D.; Athappan, P.; Rajesh, J. Synthesis and characterization of water-soluble copper (II), cobalt (II) and zinc (II) complexes derived from 8-hydroxyquinoline-5-sulfonic acid: DNA binding and cleavage studies. Appl. Organometal. Chem. 2017, 31, e3708. [Google Scholar] [CrossRef]
- Jiang, F.J.; Xue, W.D. Preparation of Tris (8-Hydroxyquinoline-5-Sulfonic Acid) Iron (III) Complex and Photocatalytic Property of Surface Modified TiO2. Adv. Mater. Res. 2011, 399, 1481–1486. [Google Scholar] [CrossRef]
- Korsmeyer, R.W.; Gurny, R.; Doelker, E.; Buri, P.; Peppas, N.A. Mechanisms of solute release from porous hydrophilic polymers. Int. J. Pharm. 1983, 15, 25–35. [Google Scholar] [CrossRef]
- Abdelwahab, S.; Abdul, A.B.; Al-Zubairi, A.; Elhassan, M.M.; Mohan, S. In Vitro Ultramorphological Assessment of Apoptosis Induced by Zerumbone on (HeLa). J. Biomed. Biotechnol. 2009, 2009, 1–10. [Google Scholar] [CrossRef]
- Tsai, S.C.; Lu, C.C.; Lee, C.Y.; Lin, Y.C.; Chung, J.G.; Kuo, S.C.; Amagaya, S.; Chen, F.N.; Chan, S.F.; Yang, J.S.; et al. AKT serine/threonine protein kinasemodulates bufalin-triggered intrinsic pathway of apoptosis in CAL 27 humanoral cancer cells. Int. J. Oncol. 2012, 41, 1683–1692. [Google Scholar] [CrossRef] [PubMed][Green Version]
- Sureshkumar, B.; Mary, Y.S.; Panicker, C.Y.; Resmi, K.; Suma, S.; Armaković, S.; Armaković, S.; Van Alsenoy, C. Spectroscopic analysis of 8-hydroxyquinoline-5-sulphonic acid and investigation of its reactive properties by DFT and molecular dynamics simulations. J. Mol. Struct. 2017, 1150, 540–552. [Google Scholar] [CrossRef]
- Koosha, M.; Mirzadeh, H. Electrospinning, mechanical properties, and cell behavior study of chitosan/PVA nanofibers. J. Biomed. Mater. Res. A 2015, 103, 3081–3093. [Google Scholar] [CrossRef] [PubMed]
- Kim, C.H.; Khil, M.S.; Kim, H.Y.; Lee, H.U.; Jahng, K.Y. An improved hydrophilicity via electrospinning for enhanced cell attachment and proliferation. J. Biomed. Mater. Res. B Appl. Biomater. 2006, 78, 283–290. [Google Scholar] [CrossRef]
- Brunetti, B.; De Giglio, E.; Cafagna, D.; Desimoni, E. XPS analysis of glassy carbon electrodes chemically modified with 8-hydroxyquinoline-5-sulphonic acid. Surf. Interface Anal. 2011, 44, 491–496. [Google Scholar] [CrossRef]
- Ruangchuay, L.; Schwank, J.; Sirivat, A. Surface degradation of α-naphthalene sulfonate-doped polypyrrole during XPS characterization. Appl. Surf. Sci. 2002, 199, 128–137. [Google Scholar] [CrossRef]
- Fujiwara, M.; Matsushita, T.; Ikeda, S. X-Ray Photoelectron Spectroscopy of Copper (II) Complexes with Donor Sets of O4, N2O4, N2O2, N4, N2S2, and S4. Anal. Sci. 1993, 9, 289–291. [Google Scholar] [CrossRef]
- Rashid, S.; Shen, C.; Chen, X.; Li, S.; Chen, Y.; Wen, Y.; Liu, J. Enhanced catalytic ability of chitosan–Cu–Fe bimetal complex for the removal of dyes in aqueous solution. RSC Adv. 2015, 5, 90731–90741. [Google Scholar] [CrossRef]
- Hajipour, A.R.; Mohammadsaleh, F.; Sabzalian, M.R. Copper-containing polyvinyl alcohol composite systems: Preparation, characterization and biological activity. J. Phys. Chem. Solids 2015, 83, 96–103. [Google Scholar] [CrossRef]
- Linga Raju, C.; Rao, J.L.; Gopal, N.O.; Reddy, B.C.V. Electron paramagnetic resonance and optical absorption studies of Cu2+ ion doped polyvinyl alcohol films. Mater. Chem. Phys. 2007, 101, 423–427. [Google Scholar] [CrossRef]
- Rao, T.R.; Omkaram, I.; Brahmam, K.V.; Raju, C.L. Role of copper content on EPR, susceptibility and optical studies in poly (vinylalcohol) (PVA) complexed poly (ethyleneglycol) (PEG) polymer films. J. Mol. Struct. 2013, 1036, 94–101. [Google Scholar] [CrossRef]
- Kokoszka, G.F.; Allen, H.C., Jr.; Gordon, G. Electron paramagnetic resonance spectrum of Bis-8-hydroxyquinolate copper (II) dihydrate. J. Chem. Phys. 1965, 42, 3730–3731. [Google Scholar] [CrossRef]
- Schlick, S. Binding sites of Cu2+ in chitin and chitosan. An electron spin resonance study. Macromolecules 1986, 19, 192–195. [Google Scholar] [CrossRef]
- Pawlicka, A.; Mattos, R.; Tambelli, C.; Silva, I.; Magon, C.; Donoso, J.P. Magnetic resonance study of chitosan bio-membranes with proton conductivity properties. J. Membr. Sci. 2013, 429, 190–196. [Google Scholar] [CrossRef]
- Trikkaliotis, D.G.; Christoforidis, A.K.; Mitropoulos, A.C.; Kyzas, G.Z. Adsorption of copper ions onto chitosan/poly(vinyl alcohol) beads functionalized with poly (ethylene glycol). Carbohydr. Polym. 2020, 234, 115890. [Google Scholar] [CrossRef]
- Chatterjee, D.; Moulik, S.K.; Giribabu, L.; Kanaparthi, R.K. Dye sensitization of a large band gap semiconductor by an iron (III) complex. Transit. Met. Chem. 2014, 39, 641–646. [Google Scholar] [CrossRef]
- Sadri, M.; Mohammadi, A.; Hosseini, H. Drug release rate and kinetic investigation of composite polymeric nanofibers. Nanomed. Res. J. 2016, 1, 112–121. [Google Scholar] [CrossRef]
- Amiri, N.; Ajami, S.; Shahroodi, A.; Jannatabadi, N.; Darban, S.A.; Bazzaz, B.S.F.; Pishavar, E.; Kalalinia, F.; Movaffagh, J. Teicoplanin-loaded chitosan-PEO nanofibers for local antibiotic delivery and wound healing. Int. J. Biol. Macromol. 2020, 162, 645–656. [Google Scholar] [CrossRef] [PubMed]
- Vanparia, S.F.; Patel, T.S.; Sojitra, N.A.; Jagani, C.L.; Dixit, B.C.; Patel, P.S.; Dixit, R.B. Synthesis, characterization and antimicrobial study of novel 4-{[(8-Hydroxyquinolin-5-yl)methyl]amino}benzenesulfonamide and its oxinates. Acta Chim. Slov. 2010, 57, 600–667. [Google Scholar]
- Anjaneyulu, Y.; Rao, R.P.; Swamy, R.Y.; Eknath, A.; Rao, K.N. In Vitro antimicrobial-activity studies on the mixed ligand complexes of Hg (II) with 8-hydroxyquinoline and salicylic acids. Proc. Indian Acad. Sci. (Chem. Sci.) 1982, 91, 157–163. [Google Scholar]
- Albert, A.; Gibson, M.I.; Rubbo, S.D. The influence of chemical constitution on antibacterial activity. VI. The bactericidal action of 8-hydroxyquinoline (oxine). Br. J. Exp. Pathol. 1953, 34, 119–130. [Google Scholar]

| Cu2+ Complex | gII | AII (mT) | g⊥ |
|---|---|---|---|
| Cu2+-SQ (this work) | 2.290 | 15.0 | 2.050 |
| * Cu2+-8-hydroxyquinoline [64] | 2.287 | 16.3 | 2.066 |
| Cu2+-PVA (this work) | 2.350 | 13.5 | 2.069 |
| * Cu2+-PVA [62] | 2.322 | 10.8 | 2.069 |
| * Cu2+-PVA [63] | 2.320 | 11.2 | 2.060 |
| Cu2+-PVA, Ch (4O)(this work) | 2.330 | 12.0 | 2.069 |
| * Cu2+-Ch, (4N) [65] | 2.244 | 17.5 | 2.069 |
| * Cu2+-Ch, (2N,2O) [66] | 2.254 | 16.2 | 2.061 |
Publisher’s Note: MDPI stays neutral with regard to jurisdictional claims in published maps and institutional affiliations. |
© 2021 by the authors. Licensee MDPI, Basel, Switzerland. This article is an open access article distributed under the terms and conditions of the Creative Commons Attribution (CC BY) license (https://creativecommons.org/licenses/by/4.0/).
Share and Cite
Ignatova, M.; Manolova, N.; Rashkov, I.; Markova, N.; Kukeva, R.; Stoyanova, R.; Georgieva, A.; Toshkova, R. 8-Hydroxyquinoline-5-Sulfonic Acid-Containing Poly(Vinyl Alcohol)/Chitosan Electrospun Materials and Their Cu2+ and Fe3+ Complexes: Preparation, Antibacterial, Antifungal and Antitumor Activities. Polymers 2021, 13, 2690. https://doi.org/10.3390/polym13162690
Ignatova M, Manolova N, Rashkov I, Markova N, Kukeva R, Stoyanova R, Georgieva A, Toshkova R. 8-Hydroxyquinoline-5-Sulfonic Acid-Containing Poly(Vinyl Alcohol)/Chitosan Electrospun Materials and Their Cu2+ and Fe3+ Complexes: Preparation, Antibacterial, Antifungal and Antitumor Activities. Polymers. 2021; 13(16):2690. https://doi.org/10.3390/polym13162690
Chicago/Turabian StyleIgnatova, Milena, Nevena Manolova, Iliya Rashkov, Nadya Markova, Rositsa Kukeva, Radostina Stoyanova, Ani Georgieva, and Reneta Toshkova. 2021. "8-Hydroxyquinoline-5-Sulfonic Acid-Containing Poly(Vinyl Alcohol)/Chitosan Electrospun Materials and Their Cu2+ and Fe3+ Complexes: Preparation, Antibacterial, Antifungal and Antitumor Activities" Polymers 13, no. 16: 2690. https://doi.org/10.3390/polym13162690
APA StyleIgnatova, M., Manolova, N., Rashkov, I., Markova, N., Kukeva, R., Stoyanova, R., Georgieva, A., & Toshkova, R. (2021). 8-Hydroxyquinoline-5-Sulfonic Acid-Containing Poly(Vinyl Alcohol)/Chitosan Electrospun Materials and Their Cu2+ and Fe3+ Complexes: Preparation, Antibacterial, Antifungal and Antitumor Activities. Polymers, 13(16), 2690. https://doi.org/10.3390/polym13162690

